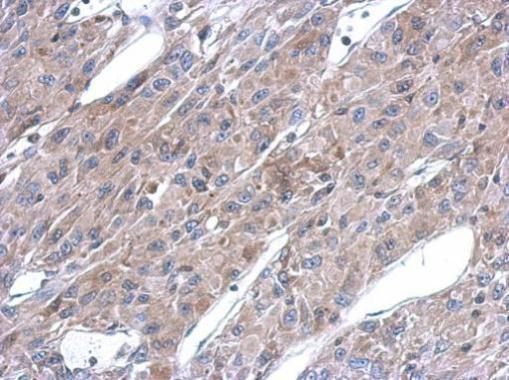
产品细节图片4

相关产品推荐更多 >

phospho-AKT1+AKT2+AKT3 (Tyr315+316+312) Antibody (BF350) 抗体,orb1586386,Biorbyt
¥4796
ADAMTS4 polyclonal antibody 抗体,orb1787317,Biorbyt
¥3509
TJP1 Antibody - middle region : FITC 抗体,orb2131558,Biorbyt
¥8216
TSGA10IP Antibody - N-terminal region : Biotin 抗体,orb2084812,Biorbyt
¥8216
P2Y6 Rabbit mAb抗体,orb1565475,biorbyt
¥1560
万千商家帮你免费找货
0 人在求购买到急需产品
- 详细信息
- 文献和实验
- 技术资料
- 抗体名:
ASL antibody抗体
- 抗体英文名:
ASL antibody
- 靶点:
ASL
- 浓度:
1.36 mg/ml
- 应用范围:
ICC, IHC-P, WB
- 宿主:
Rabbit
- 适应物种:
Human, Mouse
- 保质期:
6-12个月
- 抗原来源:
详询
- 目录编号:
orb556875
- 级别:
科研级
- 库存:
88
- 供应商:
biorbyt
- 标记物:
Unconjugated
- 克隆性:
Polyclonal
- 形态:
Liquid: 1XPBS, 20% Glycerol (pH7). 0.025% ProClin 300 was added as a preservative.
- 亚型:
IgG
- 免疫原:
Recombinant protein encompassing a sequence within the center region of human ASL. The exact sequence is proprietary.
- 规格:
100 ul
别名:argininosuccinate lyase , ASAL
免疫原:Recombinant protein encompassing a sequence within the center region of human ASL. The exact sequence is proprietary.
分子量:52
应用稀释比例:WB: 1:500-1:3000 , IF: 1:100-1:1000 , IHC-P: 1:100-1:1000
应用注释:Positive control: Neuro2A , GL261 , C8D30 , NIH-3T3 , BCL-1 , Raw264.7
纯度:Purified by antigen-affinity chromatography.
防腐剂:0.025% ProClin 300. 1XPBS (pH7), 1% rAlbumin, 20% Glycerol
纯化:Purified by antigen-affinity chromatography.
保存说明:Store as concentrated solution. Centrifuge briefly prior to opening vial. For short-term storage (1-2 weeks), store at 4°C. For long-term storage, aliquot and store at -20°lC or below. Avoid multiple freeze-thaw cycles.
UniProt ID:P04424
Note:For research use only.

风险提示:丁香通仅作为第三方平台,为商家信息发布提供平台空间。用户咨询产品时请注意保护个人信息及财产安全,合理判断,谨慎选购商品,商家和用户对交易行为负责。对于医疗器械类产品,请先查证核实企业经营资质和医疗器械产品注册证情况。
 文献和实验
文献和实验Methods for ASL Measurements and Mucus Transport Rates in Cell Cultures
The healthy human respiratory tract is lined with a pseudostratified epithelia composed of ∼80% ciliated cells and ∼20% goblet cells. These cells produce and are bathed by a layer of airway surface liquid (ASL), which plays a critical role
3 分线外挣扎的你,看别人如何登顶 Nature、Science
- 转运的离子通道。上篇:2012 Nature正片由楔子和四幕构成,前情交代 CF 模型猪和杀菌能力检测手段后,进入正戏。最终证明,CFTR 使 HCO3-转运减少,ASL pH 下降,而影响气道 ASL 中的抗菌物质的杀菌能力。楔子 隆重推出 CFTR 缺陷基因猪和抗菌检测金属网格突破 1建立了 CFTR 基因缺陷的 CF 模式猪突破 2金网格活体杀菌能力测量单个细菌依次固定在金网格薄片上 (Fig. 1a,b),放入气道,以此测定气道杀菌能力。通过生物素-链霉亲和素(biotin
Quantitative Perfusion Imaging Using Arterial Spin Labeling
labeling (ASL), in which endogenous water is made a freely diffusible perfusion tracer by perturbing the magnetization of blood water in arteries prior to their entry into tissue of interest. The technique is totally noninvasive and allows repeated
 技术资料
技术资料暂无技术资料 索取技术资料






